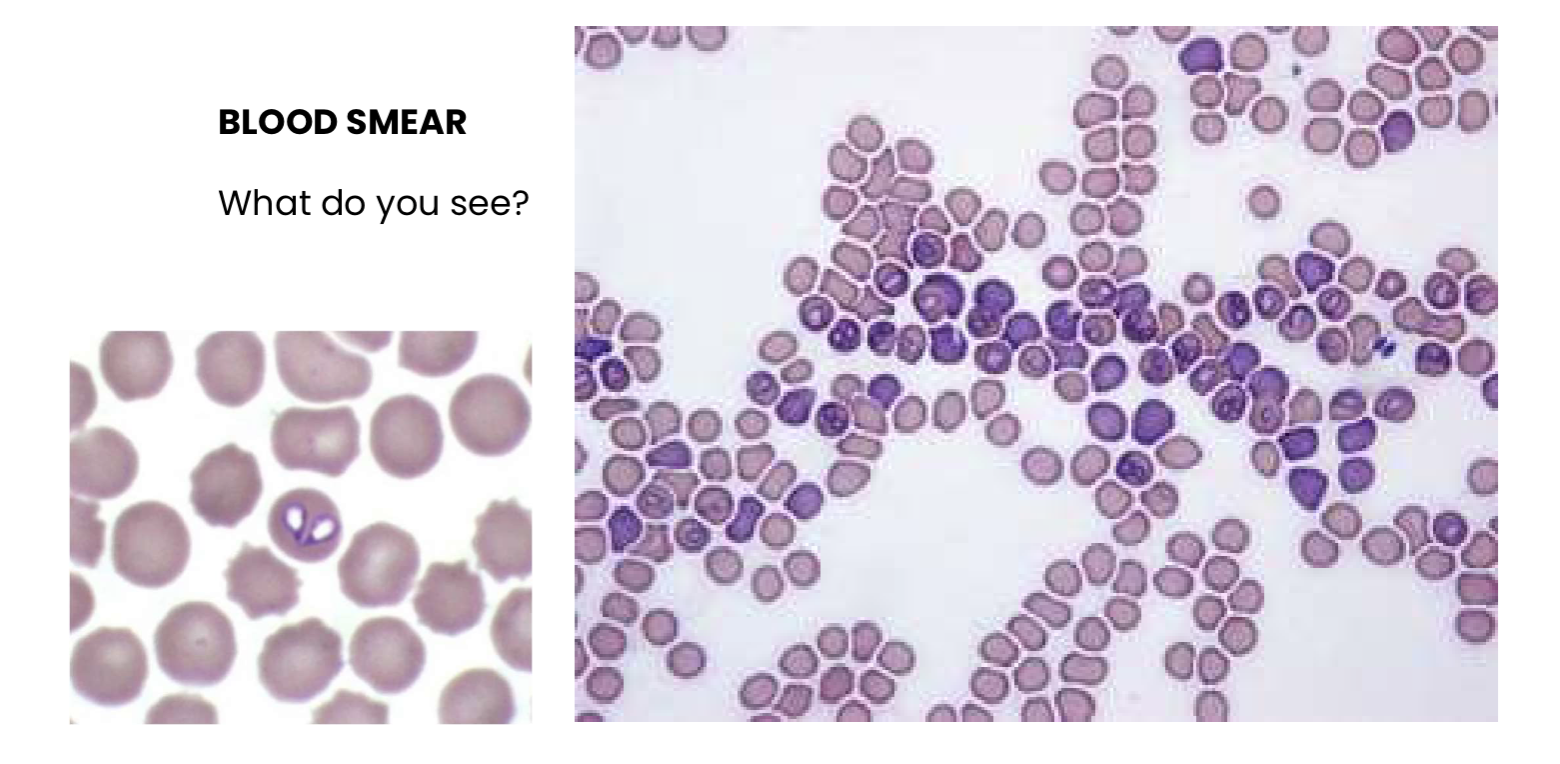
<p>Q1. What do you see?</p><p>Q2. <span>Which is the most likely etiology for haemolytic anemia in this case?</span></p>
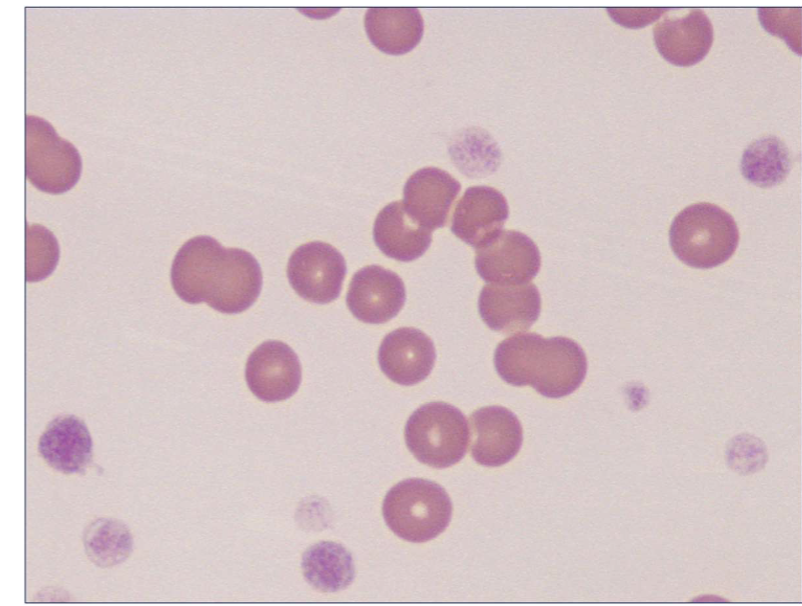
<ul><li><p>Microcytic, hypochromic non regenerative anaemia, hypoproteinemia (low PTP value) </p></li><li><p><span style="font-size: calc(var(--scale-factor)*17.52px);">Non inflammatory/infectious leucogram - <strong>right shift (likely,</strong></span><strong><br></strong><span style="font-size: calc(var(--scale-factor)*17.52px);"><strong>chronic disease)</strong></span></p></li><li><p><span style="font-size: calc(var(--scale-factor)*17.52px);">Image shows: microcytosis</span></p></li></ul><p><span>NON REGENERATIVE ANEMIA DUE TO MALABSORPTION SECONDARY TO EPI</span></p>
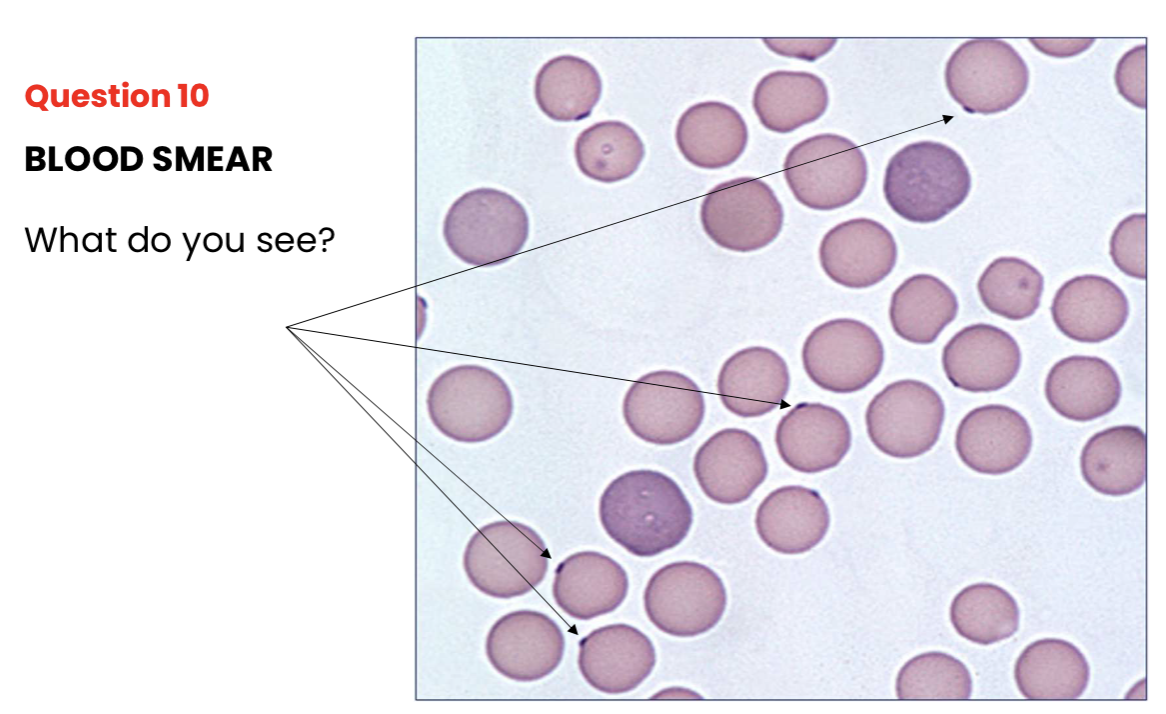
<p>What do you see?</p>

GP practical exam completed
1/274
There's no tags or description
Looks like no tags are added yet.
Name | Mastery | Learn | Test | Matching | Spaced | Call with Kai |
|---|
No analytics yet
Send a link to your students to track their progress
275 Terms
What are the three primary methods for obtaining a urine sample, and which is required for a culture and sensitivity test?
The methods are free catch (voided), urethral catheterization, and cystocentesis. If a culture is needed, cystocentesis is the only choice to ensure a sterile sample
How can you distinguish between hematuria, hemoglobinuria, and myoglobinuria based on urine appearance after centrifugation?
Hematuria: The urine clears with centrifugation as red blood cells (RBCs) form a sediment
Hemoglobinuria & Myoglobinuria: The urine remains red/brown and does not clear with centrifugation
Which animal species naturally has cloudy, mucus-filled urine containing calcium carbonate crystals?
The horse
What equipment is used to measure Urine Specific Gravity (USG), and what does it indicate?
A refractometer. USG indicates how well the kidneys can concentrate or dilute urine, providing information on renal function and hydration status

Define "Relative Polycythemia" in terms of Packed Cell Volume (PCV) and Total Protein (TP).
Relative polycythemia is characterized by an increased PCV accompanied by increased TP and clinical symptoms of dehydration
What are three morphological signs of regenerative anemia visible on a blood smear?

Anisocytosis (variation in cell size), polychromasia (immature bluish RBCs), and the presence of Howell-Jolly bodies(nuclear fragments).
How do you classify an anemia that has a low Mean Corpuscular Volume (MCV) and low Mean Corpuscular Hemoglobin Concentration (MCHC)?
It is classified as microcytic hypochromic anemia, which is typically associated with iron deficiency
Why are reticulocytes not used to assess regeneration in horses?
Horses do not release reticulocytes into peripheral blood, even during active regeneration
Which tests are used to evaluate Primary vs. Secondary Hemostasis?
Primary: Platelet count and Mucosal Bleeding Time (MBT).
Secondary: Prothrombin Time (PT) (extrinsic pathway) and Activated Partial Thromboplastin Time (APTT)(intrinsic pathway)
What is the significance of a high D-dimer or Fibrin Degradation Product (FDP) result?
It indicates active fibrinolysis (clot dissolution) and is commonly associated with Disseminated Intravascular Coagulation (DIC), sepsis, or severe hepatic disease
Where are the standard ECG electrodes (Yellow, Red, Green, Black) placed on a dog?
Yellow: Left foreleg (elbow/axilla).
Red: Right foreleg.
Green: Left hind leg (groin).
Black: Right hind leg.
What are ethologies of non-regenerative anemia?
Liver insufficiency
Chronic kidney disease
Pancreatic insufficiency
A high number of BAND NF (immature neutrophils) on a hemogram indicates…
LEFT shift
NEUTROPHILIA
Signaling acute infection or inflammation
Indicating active bacterial infection or severe inflammation.
Severe tissue necrosis, or myeloid hyperplasia.
Increased oxygen affinity (harder to release oxygen to tissues), caused by low temperature, low PCO2, low 2,3-DPG, or high pH (alkalosis).
A high number of SEG NF (mature neutrophils) on a hemogram indicates…
A RIGHT shift
HYPERSEGMENTATION
Often indicating vitamin B12 or folate deficiency
Decreased oxygen affinity (easier to release oxygen to tissues), caused by high temperature, high PCO2, high 2,3-DPG, or low pH (acidosis)
Megaloblastic anemia (e.g., 𝐵12 deficiency), chronic infections
Low PLT (plasma total proteins) on a hemogram indicates…
Thrombocytopenia

Q1. What does this hemogram show?
Q2. What is the most likely etiology for the low plasma proteins in this case?
Q3. Finally, what is the conclusion?
Macrocytic, Normochromic Regenerative anaemia, Inflammatory / infectious leukogram, LEFT SHIFT regenerative, Hypoproteinemia
Haemorrhage
Anemia secondary to gastric haemorrhage


Q1. What does this hemogram show?
Q2. What is the likely ethology for this anemia?
Q3. Finally, what is the conclusion?
Macrocytic, normochromic, regenerative anemia (Left shift)
Haemolytic anemia (jaundice)
Thromobocytopenia

Signs of haemolytic anemia vs. anemia secondary to gastric haemorrhage
Hemolytic anemia: Characterized by the destruction of red blood cells (RBCs) —> Jaundice and dark urine
Anemia secondary to gastric hemorrhage: Caused by active blood loss into the digestive tract, resulting in stool changes and signs of blood loss
What is the most likely etiology of haemolytic anemia?
Idiopathic

Q1. What does this hemogram show?
Q2. What is the ethology of this anemia?
Q3. Finally, what is the conclusion?
Macrocytic, normochromic, regenerative anemia (left shift)
Haemolytic anemia
Thrombocytopenia

Q1. What do you see?
Q2. Which is the most likely etiology for haemolytic anemia in this case?
Babes canis
Hemoparasites
HEMOLYTIC ANEMIA DUE TO BABESIA CANIS INFECTION

Q1. What does this hemogram show?
Q2. What is the ethology of this anemia?
Q3. Finally, what is the conclusion?
Microcytic, hypochromic non regenerative anaemia, hypoproteinemia (low PTP value)
Non inflammatory/infectious leucogram - right shift (likely,
chronic disease)Image shows: microcytosis
NON REGENERATIVE ANEMIA DUE TO MALABSORPTION SECONDARY TO EPI

Q1. What does this hemogram show?
Q2. What is the ethology of this anemia?
Q3. Finally, what is the conclusion?
Macrocytic, normochromic regenerative anaemia (right shift)
Stress leukogram (leukocytosis, neutrophilia, lymphopenia and eosinopenia)
Normal PTP (total plasma protein) value on a hemogram indicates….
Haemolytic anemia

What do you see?
Reticulocytes
What do you see?
Heinz bodies

What kind of anemia?
HEMOLYTIC ANEMIA SECONDARY TO KETONE BODIES ACCUMULATION
Define pulmonary emphysema and its primary pathophysiological mechanism.
It is the abnormal, permanent enlargement of air spaces distal to the terminal bronchiole accompanied by the destruction of alveolar septal walls. The mechanism involves air entering the alveoli during inspiration but becoming trapped during expiration because damaged bronchial walls collapse.
What are the classic clinical signs of emphysema on physical exam?
Expiratory dyspnea, a dry cough, and a tympanic sound on percussion (due to trapped air)
Differentiate between a Transudate and an Exudate in pleural effusion based on laboratory findings.
Transudate: Clear/light yellow, no odor, density < 1017, proteins < 3 g/dl, and leukocytes < 1500/ml
Exudate: Cloudy/opaque, variable color, bad odor, density > 1017, proteins > 3 g/dl, and leukocytes > 7000/ml
Define Hemothorax and Chylothorax
Hemothorax is bleeding into the pleural space (often from trauma or tumors).
Chylothorax is the accumulation of lymph fluid due to lymphatic drainage obstruction (e.g., lymphoma).
What is the hallmark of pulmonary fibrosis and which dog breed is genetically predisposed?
It is the replacement of lung parenchyma with scarring/fibrous tissue. It is often idiopathic and particularly common in West Highland White Terriers (WHWT)
What unique auscultation finding is associated with fibrosis?
Increased respiratory sounds specifically described as crackles
How does a mediastinal mass lead to Horner’s Syndrome?
The mass causes neurologic compression of the sympathetic trunk. Signs include ptosis (drooping eyelid), miosis (constricted pupil), and enophthalmos (sunken eye)
Why might a dog with a mediastinal mass present with regurgitation?
The mass causes digestive compression of the esophagus
What is Pneumonic Syndrome (Pulmonary Condensation)?
A pathology where air within the alveoli is replaced by a solid or fluid mix, such as dense inflammatory exudate, blood, or tumor cells
What are the physical exam findings for lung consolidation?
Dull percussion, decreased vesicular murmur, and a decrease in thorax mobility
What are the three main etiologies (causes) of atelectasis?
*the partial or complete collapse of a lung or its lobes, occurring when tiny air sacs (alveoli) within the lung deflate or fill with fluid
Contraction: Due to a lack of surfactant.
Resorption/Obstructive: Complete obstruction of a bronchiole leading to air absorption.
Compressive: External pressure from tumors or pleural effusion
Distinguish between the two types of Traumatic Pneumothorax
Open pneumothorax is caused by penetrating wounds (e.g., bite or gunshot)
Closed pneumothorax is caused by internal blunt force trauma leading to a breakage in the trachea or lung parenchyma
What is a common iatrogenic cause of pneumothorax in cats?
Trachea breakage caused by excessive pressure in the endotracheal (ET) tube balloon during intubation
What are the three hallmark clinical signs of Horner’s Syndrome caused by a mediastinal mass?
Ptosis (drooping eyelid), Miosis (constricted pupil), and Enophthalmos (sunken eye).
What is "Cranial Vena Cava Syndrome" and how does it manifest?
It is caused by a mediastinal mass compressing the cranial vena cava, leading to edema in the head, neck, and forelimbs
In Pneumonic Syndrome (Condensation), what replaces the air in the alveoli?
Air is replaced by a solid/fluid mix, which can be dense inflammatory exudate (pneumonia), tumor masses, or blood (hemorrhage).
What are the two types of Spontaneous Pneumothorax?
Primary, which occurs in otherwise healthy animals and is commonly idiopathic;
Secondary, which results from previous lung diseases like pneumonia, abscesses, or tumors
What auscultation finding is characteristic of Pulmonary Fibrosis?
Increased respiratory sounds specifically described as crackles
How does "Resorption Atelectasis" occur?
It is caused by the complete obstruction of a bronchiole, which leads to the resorption of the air already in the alveoli, causing that section of the lung to collapse
What are the three primary types of Pleural Effusion based on etiology?
1. Transudate/Exudate: Fluid from pressure changes or inflammation.
2. Hemothorax: Blood from trauma, tumors, or coagulopathies.
3. Chylothorax: Lymphatic fluid from drainage obstruction (e.g., lymphoma)
Why is a "closed" traumatic pneumothorax different from an "open" one?
An Open pneumothorax involves a penetrating wound (bite, gunshot), while a Closed pneumothorax is due to internal blunt force trauma causing a breakage in the trachea or lung parenchyma
What are the physical exam findings for an animal with Pleural Effusion?
Mixed (inspiratory) dyspnea, superficial/rapid breathing, an overinflated chest, dull sound on percussion, and reduced lung sounds on auscultation
When performing urinalysis in small animals
We must always use the refractometer when measuring the urine specific gravity
A refractometer is the gold standard for measuring the concentration of urine.
"P mitral" (a wide P-wave) indicates…

left atrial enlargement
At a paper speed of 50 mm/s, one small square (1 mm) actually represents…
0.02 seconds. The value 0.04 seconds refers to a paper speed of 25 mm/s.

New Methylene Blue (NMB) stain is used to identify reticulocytes and Heinz bodies.
cells are reticulocytes
the granules are fragments of DNA
typical of regenerative anemia

1.C, 2.D, 3.B, 4.A, 5.E (Basophil)
.
Thrombocytopenia (low platelet count) is a disorder of primary hemostasis. Secondary hemostasis refers to…
the clotting factor cascade
Prothrombin Time (PT) is used to evaluate the…
extrinsic and common pathways of the coagulation cascade (secondary hemostasis), not primary hemostasis.
APTT evaluates the…
intrinsic and common pathways. The PT test is the one that evaluates the extrinsic pathway.
Increase in creatinine kinase and aspartate aminotransferase are indicatives of…
muscle damage.
Creatinine Kinase (CK) is highly specific for muscle damage, and AST is also released during muscle cell injury
regarding liver profile analysis, AST and ALT are enzymes checking for….
hepatocellular integrity
ALT and AST are "leakage enzymes" that escape into the bloodstream when liver cells (hepatocytes) are damaged or their membranes are compromised..
liver profile. total Billirubin measurements can be divided into pre hepatic bilirubin/non-conjugated and post hepatic bilirubin/conjugated
describes the two main fractions of bilirubin measured to help determine if jaundice is caused by red blood cell breakdown (pre-hepatic) or bile duct issues (post-hepatic)

What urinary crystal is this?
Struvite

Picture B is a normal finding in horses.
Picture A (Rouleaux Formation): This image shows red blood cells stacked like coins. While this can occur in dogs due to increased plasma proteins (inflammation), it is not the "normal" state for a healthy dog.
Picture B (Agglutination): This image shows irregular clumping of red blood cells, which is a hallmark of immune-mediated hemolytic anemia in dogs. Interestingly, while this specific pattern in the image is used to contrast with Rouleaux, the exam identifies the statement that this type of distribution (Rouleaux, often confused with clumping) is a normal finding in horses as the correct factual statement among the choices.
Atrial depolarisation is represented by the…
p-wave
QRS complex represents
ventricular depolarisation
Heart electric axis represents
Its major direction of the overall electrical activity
mucosal bleeding time evaluates…
platelet function
hemoglobinuria and hematuria are commonly found in patients suffering from…
DIC
Neoplasia trauma and sepsis can induce…
disseminated intravascular coagulation syndrome (DIC)
In electrocardiopathy, the patient should be placed in…
right lateral recumbency
The usual speed for recording ECG is 50mm/s in…
dogs and cats
Spontaneous skin hematomas are a collection of blood found in the skin of patients with what kind of deficiencies?
Clotting factor deficiencies
Petechia are typically found in patients with what kind of disorders?
primary hemostasis disorders
The last stage in the coagulation process is…
fibrinolysis
A dog with rat poison intoxication will have decreased prothrombin time (PT) and
decreased activated partial thromboplastin time (APTT)
Platelet number and function are related with…
Primary hemostasis
Define hemostasis
Physiologic mechanism that stops hemorrhage and maintains blood fluidity.
What is the primary result of the "Clot" stage in the hemostasis
Platelets trapped in a mesh of fibrin fibers
What are the three stages of hemostasis illustrated in the vascular damage
Primary (vascular/platelet)
Secondary (clotting factors)
Fibrinolysis.
During stage 1 of blood coagulation, what do damaged cells and platelets produce?
Prothrombin activator (PA)
What occurs during stage 2 of blood coagulation?
Prothrombin is converted to thrombin (T) in the presence of Ca++.
What occurs during stage 3 of blood coagulation?
Fibrinogen is converted into fibrin.
What is the specific role of collagen in primary hemostasis?
Exposed collagen attracts platelets to form a platelet plug.
What is fibrinolysis?
The process of clot dissolution.
Which clotting factor initiates the extrinsic pathway following trauma?
Tissue thromboplastin (Factor III).
Which factors belong to the intrinsic pathway?
Factors XII, XI, IX, and VIII. (12, 11, 9, 8)
Which factors belong to the common pathway?
*The final stage where both the extrinsic and intrinsic pathways converge
Factors X, V, II (Prothrombin), and I (Fibrinogen).
Factor XII is activated by what type of damage?
Surface damage.
What is the active form of Factor I?
Fibrin (Ia).
What is the active form of Factor II?
Thrombin (IIa).
Which factor is responsible for stabilizing the fibrin clot?
Factor XIII.
Which test evaluates the extrinsic and common pathways?
Prothrombin Time (PT)
Which test evaluates the intrinsic and common pathways?
Activated Partial Thromboplastin Time (APTT).
What does Thrombin Time (TT) measure?
The quantity and quality of fibrinogen (the terminal common pathway).
What do FDP (D-dimers) tests detect?
Clotting dissolution (fibrinolysis)
How is the manual platelet count calculated from a 100x field?
n∘PLT/µL=(PLT number per field)×15,000.
What is the normal platelet count range for dogs and cats?
200,000 to 500,000 / mm3.
What is the normal range for platelets per field in a horse?
7 to 20 platelets per field
Define "Moderate Thrombocytopenia" and its clinical implication
40,000 – 100,000 / μl; bleeding may be present.
Define "Severe Thrombocytopenia" and its clinical implication.
< 40,000 / μl; spontaneous bleeding occurs
Name three causes of low platelet production.
Bone marrow disease, chemotherapy, and viral infections like FIV or FeLV.